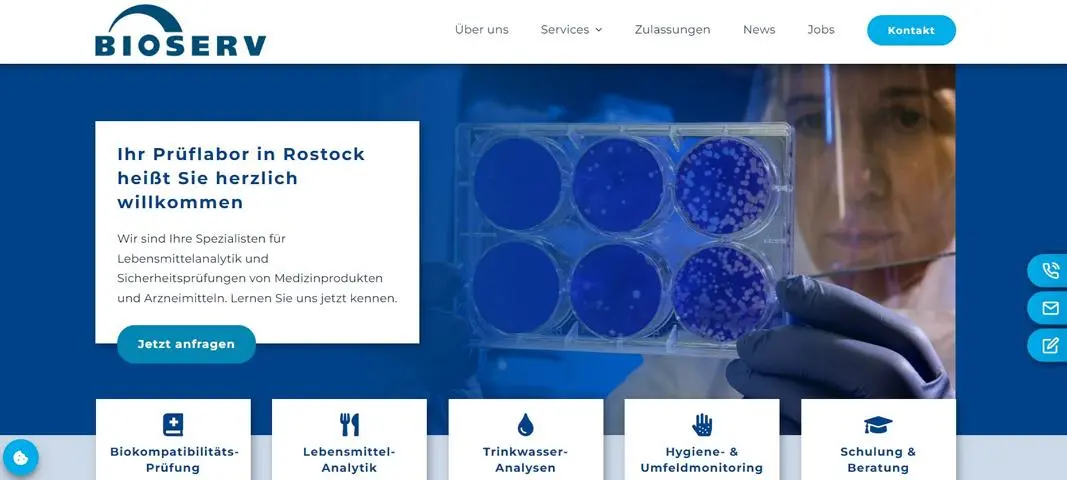
Bioserv Prüflabor in Rostock

Eine neue Webseite für Prüflabor Bioserv in Rostock
Als Prüflabor bietet Bioserv zahlreiche Services, die es galt auf der Webseite möglichst übersichtlich darzustellen. In gemeinsamer Zusammenarbeit haben wir ein Layout designt, dass die Farben und Schriften des Unternehmens widerspiegelt und dabei noch absolut seriös wirkt.
Natürlich ist auch diese WordPress Webseite mit Avada 100% individuell gestaltet worden und besticht durch eine Sidebar, schnelle Ladezeit und viele weitere Funktionen wie Cookie Banner, Tracking-Anbindung, Mobile und SEO Optimierung.
Ich freue mich schon darauf die Bioserv Webseite bald auch in Polnisch und Englisch übersetzen zu dürfen. Doch zuerst einmal wünsche ich dem sympathischen Familienunternehmen ganz viel Erfolg mit der neuen Webseite!